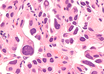

Artificial intelligence reduces false positive screens for lung cancer
Newswise | Mar 15, 2019
Targeting an 'energy crisis' in the treatment of non-small cell lung cancer
Newswise | Jan 30, 2019
Molecular profiling could catch lung cancer early and lead to new treatments
Newswise | Jan 23, 2019
Lung transplant patients face elevated lung cancer risk
Wiley | Dec 21, 2018
MD Anderson study shows key enzyme linked to therapy resistance in deadly lung cancer
Newswise | Dec 12, 2018